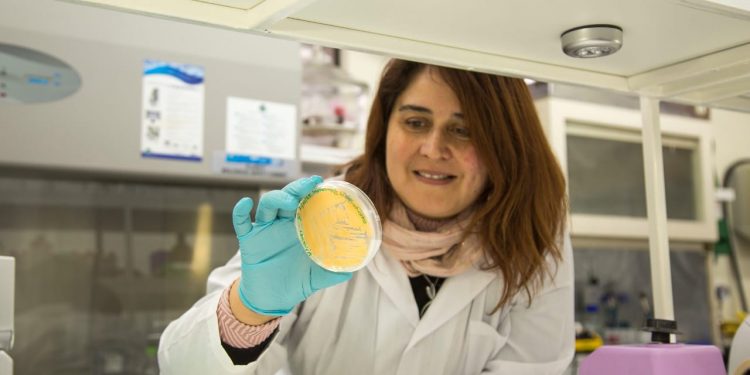
Hacen llamado a incorporar a las pymes en los procesos de aplicación de nuevas tecnologías

¿Cómo influye la tecnología en un país? ¿Cuál es el efecto que estos avances tienen en las empresas o pymes? ¿Cómo se pueden aprovechar estos descubrimientos para avanzar hacia el desarrollo? fueron algunas de las preguntas tratadas en la tercera edición del “Sunset de Innovación”, Suntech Valpo 2020, encuentro de transferencia tecnológica -el que se desarrolló por primera vez 100% digital-, que presentó 30 soluciones desarrolladas por investigadores a representantes de empresas, inversionistas, académicos y emprendedores.
Organizado por la unión de las universidades Técnica Federico Santa María (UTFSM), Católica de Valparaíso (PUCV), de Valparaíso (UV) y el Centro Regional de Estudios en Alimentos Sustentables (CREAS), el evento buscó ser un puente entre investigadores e inventores -de la academia y organizaciones público-privadas que puedan dar un uso real y de alto impacto a estos descubrimientos.
En este contexto, una de las principales conclusiones que arrojó el Sunset de Innovación, fue la necesidad que las empresas de menor tamaño, las pymes -quienes son el mayor músculo de generación de empleos y ocupaciones del país- integren y adopten las nuevas tecnologías y soluciones, para que se transformen en el corazón del uso de las soluciones proporcionadas por la academia, para así contribuir al desarrollo de un país que genera productos de valor agregado, por sobre la venta de materias primas.
“Nuestro objetivo es tratar de unir la academia y la industria, ya que los primeros crean muchas tecnologías/resultados/innovaciones- que pueden tener un alto impacto en los segundos y ciertamente en el avance del país, al mediano y largo plazo. Creemos que esa premisa se cumplió con la amplia asistencia que tuvimos y esperamos poder seguir desarrollando este evento en el 2021 y años venideros” Sostuvo Macarena Rosenkranz, directora de la Oficina de Transferencia y Licenciamiento de la PUCV.
En este sentido, el Sunset de Innovación presentó 30 tecnologías creadas y desarrolladas por investigadores de las universidades y creas, las que fueron muy bien recibidas y percibidas por los asistentes; entre quienes estuvieron representantes de Gobierno y empresas como Enel X, Sodimac, Coca-Cola, BHP, Cellus, Agrosuper y Huawei; quienes coincidieron que muchas de estas creaciones pueden ser de gran utilidad a sus industrias y al país.
Asimismo, desde el mundo de la innovación, Ignacio Merino, director ejecutivo de Hubtec señaló “En la ecuación hemos detectado tres categorías: las universidades o centros de investigación que son los generadores del conocimiento; la otra son las grandes empresas que son las que tienen las grandes demandas; pero también hay una tercera que son las pequeñas y medianas empresas que son el músculo que logra conectar los dos mundos”.
En tanto, desde la vereda del sector privado, esta visión es compartida. Ricardo Guerra de Asiva, indica que “Hay que trabajar más para que la academia entienda la misión del empresario, quien no es solo una persona que quiere ganar dinero. El empresario soluciona muchos problemas de la sociedad, hace oferta laboral, es un actor importante del desarrollo económico social de una región o de un país, hay que trabajar juntos, no hay que mirarlo como que nosotros estamos en una cancha y el científico en otra cancha distinta, tenemos que trabajar todos en la misma cancha para el bien común”.